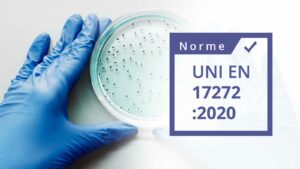
idr norme uni nf en 17272 2020

La maîtrise de l’invisible
UBIQUITY accompagne les environnements sensibles dans la mise en place de protocoles de désinfection de l’air fiables, traçables et conformes, partout en France.
Santé • Industrie • Transport • Collectivités
Ubiquity Désinfection
Bien plus qu’une solution de désinfection
Nous ne diffusons pas un produit.
Nous construisons, encadrons et validons des protocoles de désinfection adaptés à chaque site, à chaque contrainte, à chaque réglementation.
Notre mission
Sécuriser les environnements sensibles.
Notre devise
L’accompagnement comme standard.
Notre promesse
Une désinfection conforme, sans compromis.
Audit & diagnostic
Analyse des volumes, ventilation, risques, obligations réglementaires et contraintes sectorielles.
Mise en place des protocoles
Définition des cycles DSVA (continu/fractionné), paramétrage, validation.
Formation des équipes
Gestion des risques, bonnes pratiques DSVA, sécurité, procédures HACCP / ERP.
Traçabilité & conformité
Enregistrement des cycles, rapports d’exécution, suivi des paramètres critiques, archivage et conformité réglementaire française.
Des environnements où l’erreur n’est pas une option
Chaque environnement impose ses contraintes.
Nos protocoles s’y adaptent.
- Établissements de santé
- Industrie & laboratoires
- Transport & logistique
- Collectivités & ERP sensibles
Une approche structurée, de l’audit à la preuve
Comment se déroule une intervention UBIQUITY :
1. Audit et diagnostic
Volumes, ventilation et obligations réglementaires françaises.
2. Construction du protocole
Définition du cycle, paramètres et conditions de sécurité.
3. Exécution maîtrisée
Définition du cycle, paramètres et conditions de sécurité.
4. Traçabilité & conformité
Définition du cycle, paramètres et conditions de sécurité.

Certification & Patents
Une désinfection conforme, sans compromis.
Conformité
Une technologie éprouvée. Des exigences respectées.
UBIQUITY accompagne ses clients dans la mise en conformité de leurs pratiques, en intégrant la traçabilité, les données opérationnelles et la validation des cycles via sa plateforme.
Les appareils que nous intégrons sont conformes aux principales exigences réglementaires françaises et européennes.
- Obligations ARS pour les établissements de santé
- Obligations Code du Travail (risques chimiques – VLEP H₂O₂)
- HACCP pour l’agroalimentaire et les collectivités
- Obligations ERP (crèches, écoles, hôtellerie)
- Exigences logicielles / traçabilité pour les audits internes
Besoin d’un audit ou d’un protocole DSVA ?
Nos experts vous accompagnent partout en France.
Posez-nous vos questions, ou planifiez une étude de votre site.
Trouvez vos réponses
Foire aux questions
La désinfection des surfaces par voie aérienne (DSVA) au H₂O₂ ou HOCl est utilisée dans les environnements les plus exigeants : santé, collectivités, transport, industrie, laboratoires, agroalimentaire…
Nous adaptons les protocoles en fonction des volumes, de la ventilation, des contraintes réglementaires et des risques spécifiques à chaque activité.
Notre intervention suit un processus structuré :
Audit & diagnostic du site
Définition du protocole DSVA (cycles, paramètres, sécurité)
Installation & formation des équipes
Traçabilité complète via notre plateforme (rapports, archivage, conformité ARS / HACCP / audits internes)
Chaque étape est documentée pour garantir une parfaite conformité réglementaire.
Les deux désinfectants ont des usages complémentaires :
H₂O₂ 12 % : efficacité large spectre, adapté aux environnements exigeants (secteurs médicaux, paramédicaux, transport, industrie).
HOCl 500 ppm : solution plus douce, compatible ERP, crèches, établissements scolaires, collectivités et agroalimentaire.
Nos équipes vous orientent vers le désinfectant le plus adapté à votre environnement et à vos contraintes réglementaires.
Absolument. Chaque cycle DSVA génère un rapport incluant : durée, température, humidité, concentration, validation du lieu, conformité, etc. Ces données sont archivées et consultables via la plateforme Ubiquity.
